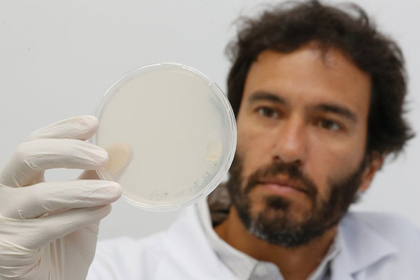
Найдено лекарство против опасных проблем с сердцем

Найдено лекарство против опасных проблем с сердцем
Найдено лекарство против опасных проблем с сердцем
Группа ученых из Бразилии и США создали молекулу SAMβA, которая останавливает развитие сердечной недостаточности и улучшает способность органа качать кровь. Лечение крыс новым препаратом в течение шести недель не только остановило болезнь, но и улучшило состояние организма благодаря укреплению мышцы сердца. Об этом сообщается в пресс-релизе на MedicalXpress.
SAMβA подавляет взаимодействие между молекулой β2PKC — протеинкиназы-С-бета-2 — и митофузина 1 (Mfn1), ключевого элемента митохондрий. β2PKC ингибирует Mfn1, не позволяя митохондриям производить энергию и ухудшает таким образом функции сердца. Известно, что избыток протеинкиназы-С-бета-2 связан с сердечной недостаточностью, и ее дезактивация улучшает состояние пациентов. Однако недостаток β2PKC может привести к другим нежелательным эффектам.
Новая молекула обладает селективным воздействием, то есть она предотвращает дисфункцию митохондрий, но безопасна для других важных процессов. Для ее и тестирования поиска были проведены эксперименты с рекомбинантными белками, клеточными культурами, животными и сердечными тканями, полученными у пациентов. Изначально было найдено шесть молекул с похожими свойствами, однако только SAMβA не вступала в нежелательные взаимодействия.
SAMβA также снижает концентрацию пероксида водорода в клетках, присутствие которого связано с окислительным стрессом и повреждением клеточных компонентов, таких как белки, ДНК и липиды. У крыс, у которых был вызван инфаркт миокарда, молекула останавливала развитие сердечной недостаточности и улучшала здоровье по сравнению с контрольной группой, в которой больные животные получали плацебо.
https://lenta.ru
